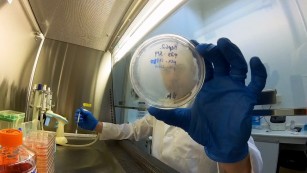
Ciência SP | Metabólitos no controle de obesidade e diabetes
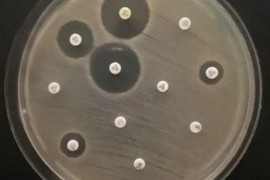
Bactérias detectadas em rio urbano, cão doméstico e lesões de pele ressaltam risco da multirresistência microbiana

Experimento com camundongos feito na Unicamp testou a ação do HMB, um derivado do aminoácido leucina já usado na preservação da massa muscular
Árvores gigantes de florestas tropicais superam limites físicos para transportar água até o topo
Estudo publicado na Science mostra que espécies com altura equivalente à de prédios de 30 andares desenvolveram adaptações internas e – ao contrário do que se pensava – não são mais vulneráveis a secas do que a vegetação mais baixa
Musculação reprograma células do fígado e ajuda a reverter danos da obesidade
Estudo da Unicamp com camundongos revela que o treinamento de força modula o genoma hepático, restaurando a sensibilidade à insulina e combatendo o acúmulo de gordura no órgão
Estudo mostra que as gramíneas e ervas não desaparecem por simples intolerância à sombra, mas sim porque a falta de luz faz com que esgotem suas reservas subterrâneas de energia
FAPESP, Unicamp e Funcamp assinam convênio de cooperação institucional
O documento estabelece diretrizes para a gestão administrativa e financeira das atividades de aquisição por importação de bens e contratação de serviços no exterior necessários à realização de pesquisas científicas
FAPESP destina R$ 50 milhões para projetos de inovação em pequenas empresas
Chamada PIPE Jornada Tecnológica oferece até R$ 500 mil por projeto; pré-propostas em todas as áreas do conhecimento serão recebidas até 29 de julho
‘Língua eletrônica’ detecta anticorpos da gripe aviária em seis minutos
Tecnologia nacional une inteligência artificial e sensores de baixo custo para monitorar o vírus H5N1 no campo com 99% de precisão
OPORTUNIDADES FAPESP
MS em química inorgânica / eletroanalítica
ICAQF-Unifesp
Inscrições até 17/07/2026
PD em recuperação avançada de petróleo
FEM-Unicamp e Poli-USP
Inscrições até 15/07/2026
MS em materiais quânticos
IF-USP
Inscrições até 17/07/2026
PD em visão computacional / robótica / IA
Embrapa Agricultura Digital
Inscrições até 17/07/2026
JC-2 em saúde pública – controle do câncer
Fundação Oncocentro
Inscrições até 15/07/2026
TT-2 em oncologia / pesquisa clínica
Icesp / HC-FM-USP
Inscrições até 17/07/2026
Vídeos
Agricultura sustentável
Desenvolvimento de Fármacos
Agenda
Encontros do Grupo de Pesquisa sobre Física Nuclear e Partículas
29/05/2026 a 31/07/2026
Manifestações artísticas no enfrentamento à repressão
27/06/2026 a 28/03/2027
Imersão em Física para OBFEP/OBF e ONC
04/07/2026 a 01/08/2026
Jornada II – A perspectiva da complexidade para abordar questões socioambientais e riscos
06/07/2026 a 08/07/2026
9º Perimeter-SAIFR-IFT Journeys into Theoretical Physics
06/07/2026 a 12/07/2026
Webinário sobre bolsas de Iniciação Tecnológica
08/07/2026 a 08/07/2026
28º Encontro USP-Escola
13/07/2026 a 17/07/2026
4ª Escola Conjunta ICTP-SAIFR/ICTP-Trieste sobre Física de Partículas
13/07/2026 a 24/07/2026
Chamadas FAPESP
Programa de Pesquisa em Políticas Públicas
Fase 2 (municipal)
Prazo: 06/07/2026
Trans-Atlantic Platform
Fase de pré-propostas
Prazo: 08/07/2026
CONFAP / European Research Comission
Prazo: 10/07/2026
Auxílio à Inovação Regular - Iniciação Tecnológica
Prazo: 13/07/2026